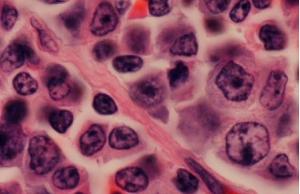

- 巨球蛋白血症

巨球蛋白血症
病因
原发性巨球蛋白血症确切的病因尚不清楚。可在家族及同卵双胞胎中发病,推测可能与遗传因素有关。环境因素、病毒感染,如肝炎病毒感染在原发性巨球蛋白血症中的发病作用尚不明确。巨球蛋白血症的治疗目前尚没有非常理想的治疗方法,通常采用烷化剂和苯丁酸氮芥治疗,中医治疗只能是对症下药,控制病情的发展,提高生存质量。
原发性巨球蛋白血症确切的病因尚不清楚。可在家族及同卵双胞胎中发病,推测可能与遗传因素有关。环境因素、病毒感染,如肝炎病毒感染在原发性巨球蛋白血症中的发病作用尚不明确。巨球蛋白血症的治疗目前尚没有非常理想的治疗方法,通常采用烷化剂和苯丁酸氮芥治疗,中医治疗只能是对症下药,控制病情的发展,提高生存质量。
症状
巨球蛋白血症的症状主要表现为以下五大类:
1.起病隐匿、缓慢,早期常无不适或乏力,体重减轻。
2.贫血、出血(常见皮肤紫癜、鼻衄)。
3.淋巴结、肝、脾肿大。
4 .部分巨球蛋白具有冷球蛋白性质可引起血管栓塞和雷诺现象。
5.高粘滞度综合征:视力障碍、一过性瘫痪,反射异常,耳聋、意识障碍甚至昏迷,亦可发生心力衰竭。
检查
1.血常规检查
2.骨髓常规检查
3.细胞化学染色
4.血清免疫学检查
5.血沉
6.尿液检查
7.肾功能检查
8.冷球蛋白检查
9.组织活检
诊断
巨球蛋白血症对某些较重的病例,应与多发性骨髓瘤、慢性淋巴细胞的血病及淋巴瘤鉴别。
治疗
 巨球蛋白血症的药物治疗尚无特效,其巨球蛋白血症的治疗为以下四点:
巨球蛋白血症的药物治疗尚无特效,其巨球蛋白血症的治疗为以下四点:
1、降低高粘滞血症,包括血浆置换术。
2、化疗。
3、对症治疗、支援治疗。
4、严重贫血者可输血和/或人体白蛋白。
并发症
巨球蛋白血症主要并发症为疾病恶化、贫血、出血、感染,也有的患者因发展为弥漫性大细胞淋巴瘤(R ichter 综合征)、急性骨髓细胞白血病而死亡。[1]

-
吉利缤越PRO家族正式上市 大众ID.7第二季度全球首发
2025-11-03 22:46:22 查看详情 -
雪铁龙凡尔赛C5 4月12日全球首秀
2025-11-03 22:46:22 查看详情 -
雪铁龙天逸BEYOND将于8月16日上市 4月12日全球首秀
2025-11-03 22:46:22 查看详情 -
雪铁龙全新标识亮相 4月12日全球首秀
2025-11-03 22:46:22 查看详情 -
雪铁龙Oli电动皮卡概念车发布 4月12日全球首秀
2025-11-03 22:46:22 查看详情 -
雪铁龙全新C3L官图泄露 4月12日全球首秀
2025-11-03 22:46:22 查看详情 -
雪铁龙爱丽舍继任者或2024年亮相 4月12日全球首秀
2025-11-03 22:46:22 查看详情 -
新款东风雪铁龙天逸C5 4月12日全球首秀
2025-11-03 22:46:22 查看详情 -
全新雪铁龙C5原型车谍照 4月12日全球首秀
2025-11-03 22:46:22 查看详情 -
新款雪铁龙C3 4月12日全球首秀
2025-11-03 22:46:22 查看详情


 求购
求购

